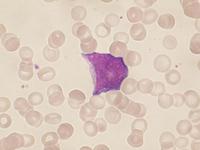
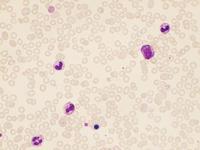

Abb. 9: In diesem Fall handelt es sich um eine schwere bakterielle Infektion bei einem Kind. Blutausstrich, Übersicht (Objektiv 20x). Neben der deutlichen Leukozytose erkennt man bereits bei dieser Vergrößerung neutrophile Grannulozyten, die Myelozyten oder Promyelozyten entsprechen dürften.

|
|
|
|